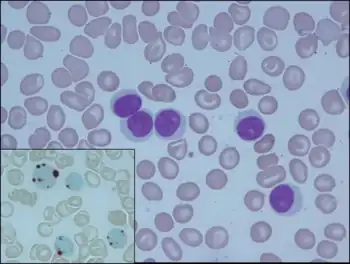

Prolymphocytic leukemia
| Prolymphocytic leukemia | |
|---|---|
![]() | |
| Medium sized lymphoid cells, with oval nucleus, a visible nucleolus and moderate amount of basophilic agranular cytoplasm | |
| Specialty | Hematology, oncology |
Prolymphocytic leukemia is divided into two types according to the kind of cell involved: B-cell prolymphocytic leukemia and T-cell prolymphocytic leukemia. It is usually classified as a kind of chronic lymphocytic leukemia.[1]
References
- ↑ Hsi, Eric D. (1 January 2012). "12 - B-Cell Leukemias of Mature Lymphocytes". Hematopathology (Second Edition). W.B. Saunders. pp. 387–402. ISBN 978-1-4377-2606-0. Archived from the original on 22 November 2021. Retrieved 22 November 2021.
External links
| Classification |
|---|
This article is issued from Wmcloud. The text is licensed under Creative Commons - Attribution - Sharealike. Additional terms may apply for the media files.